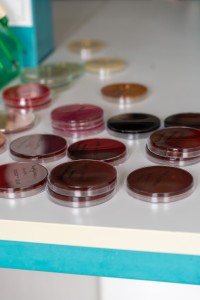
VII edycja warsztatów dla licealistów. Kliknij, aby powiększyć zdjęcie.

Z ogromną radością podsumowujemy VII edycję Praktycznych Warsztatów dla Uczniów Szkół Ponadpodstawowych, która odbyła się w dniach 22-26 września 2025 roku na terenie laboratoriów Wydziału Farmaceutycznego Collegium Medicum im. Ludwika Rydygiera w Bydgoszczy UMK w Toruniu. Wydarzenie to, skierowane do młodzieży zainteresowanej farmacją, diagnostyką laboratoryjną i kosmetologią, umożliwiło uczestnikom wzięcie udziału w 21 różnorodnych warsztatach. Były one prowadzone przez doświadczonych pracowników naukowych i dydaktycznych Wydziału, a ich celem było przybliżenie praktycznych aspektów tych dziedzin, pomagając uczniom w wyborze przyszłej ścieżki zawodowej.
Tematyka Warsztatów
W programie VII edycji znalazły się zajęcia praktyczne obejmujące kluczowe zagadnienia z nauk farmaceutycznych, diagnostyki laboratoryjnej i kosmetologii. 16 Katedr naszego Wydziału zaproponowało następujące tematy »
W praktycznych ćwiczeniach laboratoryjnych uczestniczyli Uczniowie z 23 Szkół Ponadpodstawowych z Bydgoszczy, województwa kujawsko-pomorskiego i z innych regionów Polski »
Patronaty i Współpraca
Nasza inicjatywa po raz kolejny spotkała się z prestiżowym wsparciem i została objęta Honorowym Patronatem»
Podobnie jak w poprzednich edycjach, w duchu hasła "młodzi dla młodych", organizatorów aktywnie wspierali studenci kierunków analityka medyczna, farmacja i kosmetologia.
Mamy nadzieję, że VII edycja Warsztatów utwierdziła uczestników w ich zainteresowaniach i pomogła w podjęciu świadomej decyzji o przyszłej drodze zawodowej.
Już teraz serdecznie zapraszamy na kolejne edycje!
Podziękowania
Dziękujemy wszystkim, którzy wsparli organizację warsztatów.
Prosimy o zapoznanie się z pełną treścią podziękowań »
Tak piszą o nas media i social media »


 ul. Jagiellońska 15, 85-067 Bydgoszcz,
ul. Jagiellońska 15, 85-067 Bydgoszcz,